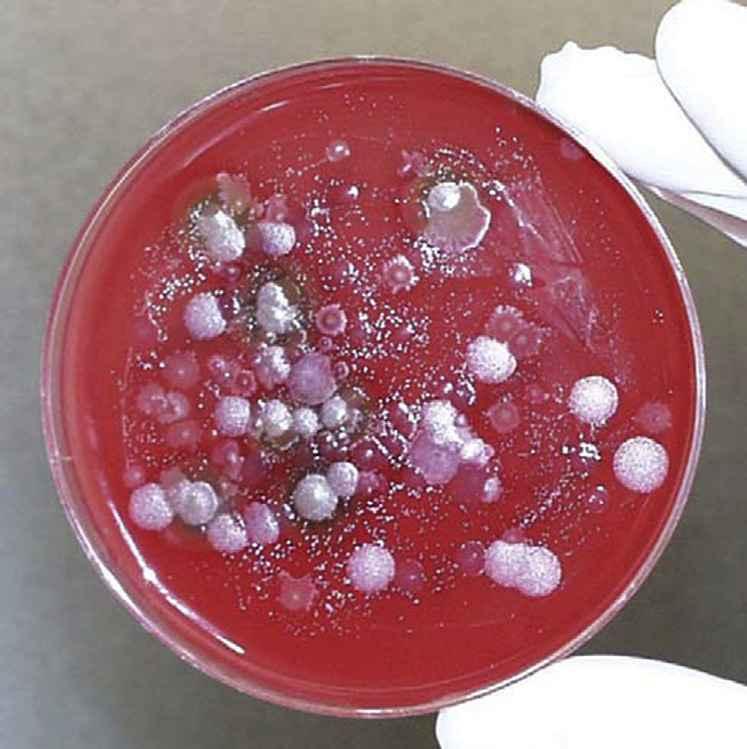

Instant digital products (PDF, ePub, MOBI) ready for you
Download now and discover formats that fit your needs...
System Forensics, Investigation, and Response (Information Systems Security & Assurance) 3rd Edition – Ebook PDF Version
https://ebookmass.com/product/system-forensics-investigation-andresponse-information-systems-security-assurance-3rd-edition-ebook-pdfversion/
ebookmass.com
Operating System Forensics 1st Edition Messier
https://ebookmass.com/product/operating-system-forensics-1st-editionmessier/
ebookmass.com
Cybercrime and Digital Forensics: An Introduction
https://ebookmass.com/product/cybercrime-and-digital-forensics-anintroduction/
ebookmass.com
MCSA 70-742 Cert Guide: Identity with Windows Server 2016 1st Edition Benjamin Finkel
https://ebookmass.com/product/mcsa-70-742-cert-guide-identity-withwindows-server-2016-1st-edition-benjamin-finkel/
ebookmass.com
A Midflight Vampire's Tale Linda Ling https://ebookmass.com/product/a-midflight-vampires-tale-linda-ling/ ebookmass.com
The Principles of Banking 2nd Edition Moorad Choudhry
https://ebookmass.com/product/the-principles-of-banking-2nd-editionmoorad-choudhry/
ebookmass.com
The False Promise of Superiority: The United States and Nuclear Deterrence after the Cold War James H. Lebovic
https://ebookmass.com/product/the-false-promise-of-superiority-theunited-states-and-nuclear-deterrence-after-the-cold-war-james-hlebovic/ ebookmass.com
The Black Mediterranean: Bodies, Borders and Citizenship Gabriele Proglio
https://ebookmass.com/product/the-black-mediterranean-bodies-bordersand-citizenship-gabriele-proglio/
ebookmass.com
Publishing in a Medieval Monastery. The View from TwelfthCentury Engelberg Benjamin Pohl
https://ebookmass.com/product/publishing-in-a-medieval-monastery-theview-from-twelfth-century-engelberg-benjamin-pohl/
ebookmass.com
The Trump Doctrine and the Emerging International System Stanley A. Renshon
https://ebookmass.com/product/the-trump-doctrine-and-the-emerginginternational-system-stanley-a-renshon/
ebookmass.com
MICROBIAL FORENSICS THIRDEDITION Editedby BruceBudowle
StevenSchutzer
StephenMorse
AcademicPressisanimprintofElsevier 125LondonWall,LondonEC2Y5AS,UnitedKingdom 525BStreet,Suite1650,SanDiego,CA92101,UnitedStates 50HampshireStreet,5thFloor,Cambridge,MA02139,UnitedStates TheBoulevard,LangfordLane,Kidlington,OxfordOX51GB,UnitedKingdom
Copyright©2020ElsevierInc.Allrightsreserved.
Nopartofthispublicationmaybereproducedortransmittedinanyformorbyanymeans,electronicormechanical,including photocopying,recording,oranyinformationstorageandretrievalsystem,withoutpermissioninwritingfromthepublisher. Detailsonhowtoseekpermission,furtherinformationaboutthePublisher’spermissionspoliciesandourarrangements withorganizationssuchastheCopyrightClearanceCenterandtheCopyrightLicensingAgency,canbefoundatourwebsite: www.elsevier.com/permissions .
ThisbookandtheindividualcontributionscontainedinitareprotectedundercopyrightbythePublisher(otherthanasmaybe notedherein).
Notices Knowledgeandbestpracticeinthis fieldareconstantlychanging.Asnewresearchandexperiencebroadenourunderstanding, changesinresearchmethods,professionalpractices,ormedicaltreatmentmaybecomenecessary.
Practitionersandresearchersmustalwaysrelyontheirownexperienceandknowledgeinevaluatingandusinganyinformation, methods,compounds,orexperimentsdescribedherein.Inusingsuchinformationormethodstheyshouldbemindfuloftheir ownsafetyandthesafetyofothers,includingpartiesforwhomtheyhaveaprofessionalresponsibility.
Tothefullestextentofthelaw,neitherthePublishernortheauthors,contributors,oreditors,assumeanyliabilityforanyinjury and/ordamagetopersonsorpropertyasamatterofproductsliability,negligenceorotherwise,orfromanyuseoroperationof anymethods,products,instructions,orideascontainedinthematerialherein.
LibraryofCongressCataloging-in-PublicationData
AcatalogrecordforthisbookisavailablefromtheLibraryofCongress
BritishLibraryCataloguing-in-PublicationData
AcataloguerecordforthisbookisavailablefromtheBritishLibrary
ISBN:978-0-12-815379-6
ForinformationonallAcademicPresspublicationsvisitour websiteat https://www.elsevier.com/books-and-journals
Publisher: StacyMasucci
AcquisitionEditor: ElizabethBrown
EditorialProjectManager: PatGonzalez
ProductionProjectManager: SuryaNarayananJayachandran
CoverDesigner: MarkRogers
TypesetbyTNQTechnologies
Contributors M.W.Allard DivisionofMicrobiology,Officeof RegulatoryScience,CFSAN,USFDA,College Park,MD,UnitedStates
JonathanAllen LawrenceLivermoreNationalLaboratory,Livermore,CA,UnitedStates
PhilipS.Amara CollegeofPublicHealth,UniversityofNebraskaMedicalCenter,Omaha,NE, UnitedStates
NeelG.Barnaby FBILaboratory,Quantico,VA, UnitedStates
JohnR.Barr CentersforDiseaseControlandPrevention,NationalCenterforEnvironmentalHealth, DivisionofLaboratorySciences,Atlanta,GA, UnitedStates
AerielBelk AnimalSciences,ColoradoStateUniversity,FortCollins,CO,UnitedStates
NicholasH.Bergman NationalBioforensicand AnalysisCenter,Frederick,MD,UnitedStates
ChristopherA.Bidwell FederationofAmerican Scientists,Washington,DC,UnitedStates
DawnBirdsell ThePathogenandMicrobiomeInstitute,NorthernArizonaUniversity,Flagstaff,AZ, UnitedStates
ThomasA.Blake CentersforDiseaseControland Prevention,NationalCenterforEnvironmental Health,DivisionofLaboratorySciences,Atlanta, GA,UnitedStates
E.W.Brown DivisionofMicrobiology,OfficeofRegulatoryScience,CFSAN,USFDA,CollegePark, MD,UnitedStates
SibylBucheli DepartmentofBiologicalSciences, SamHoustonStateUniversity,Huntsville,TX, UnitedStates
BruceBudowle CenterforHumanIdentification, DepartmentofMicrobiology,Immunologyand Genetics,UniversityofNorthTexasHealthScience Center,FortWorth,TX,UnitedStates
RobertL.Bull FBILaboratory,Quantico,VA, UnitedStates
JamesBurans NationalBioforensicandAnalysis Center,Frederick,MD,UnitedStates
DavidO.Carter LaboratoryofForensic Taphonomy,ForensicSciencesUnit,Divisionof NaturalSciencesandMathematics,Chaminade UniversityofHonolulu,Honolulu,HI,United States
AngelaChoi DepartmentofMicrobiology,Icahn SchoolofMedicineatMountSinai,NewYork, NY,UnitedStates
BrookeL.DeatherageKaiser PacificNorthwest NationalLaboratory,Richland,WA,UnitedStates
R.ScottDecker Bio-LogicSecurity,LLC,LasVegas, NV,UnitedStates
HeatherDeel AnimalSciences,ColoradoStateUniversity,FortCollins,CO,UnitedStates
DavidM.Engelthaler TGenNorth,Translational GenomicsResearchInstitute,Flagstaff,AZ,United States
HectorF.Espitia-Navarro SchoolofBiologicalSciences,GeorgiaInstituteofTechnology,Atlanta, GA,UnitedStates;PanAmericanBioinformatics Institute,Cali,ValledelCauca,Colombia
JacquelineFletcher DepartmentofEntomology & PlantPathology,NationalInstituteforMicrobial Forensics & FoodandAgriculturalBiosecurity, OklahomaStateUniversity,Stillwater,OK,United States
JeffreyT.Foster ThePathogenandMicrobiome Institute,NorthernArizonaUniversity,Flagstaff, AZ,UnitedStates
AdolfoGarcía-Sastre DepartmentofMicrobiology, IcahnSchoolofMedicineatMountSinai,New York,NY,UnitedStates;DepartmentofMedicine, IcahnSchoolofMedicineatMountSinai,NewYork,
NY,UnitedStates;GlobalHealthandEmerging PathogensInstitute,IcahnSchoolofMedicineat MountSinai,NewYork,NY,UnitedStates;The TischCancerInstitute,IcahnSchoolofMedicineat MountSinai,NewYork,NY,UnitedStates
JenniferS.Goodrich NationalBioforensicand AnalysisCenter,Frederick,MD,UnitedStates
BradleyHart LawrenceLivermoreNationalLaboratory,Livermore,CA,UnitedStates
DavidR.Hodge DepartmentofHomelandSecurity, Washington,DC,UnitedStates
PaulJ.Jackson AdjunctProfessor,Nonproliferation andTerrorismStudies,JamesMartinCenterfor NonproliferationStudies,MiddleburyInstituteof InternationalStudiesatMonterey,Monterey,California,UnitedStates
CrystalJaing LawrenceLivermoreNationalLaboratory,Livermore,CA,UnitedStates
RudolphC.Johnson CentersforDiseaseControl andPrevention,NationalCenterforEnvironmental Health,DivisionofLaboratorySciences,Atlanta, GA,UnitedStates
I.KingJordan SchoolofBiologicalSciences,GeorgiaInstituteofTechnology,Atlanta,GA,United States;PanAmericanBioinformaticsInstitute, Cali,ValledelCauca,Colombia;AppliedBioinformaticsLaboratory,Atlanta,GA,UnitedStates
SuzanneR.Kalb CentersforDiseaseControland Prevention,NationalCenterforEnvironmental Health,DivisionofLaboratorySciences,Atlanta, GA,UnitedStates
ArnoldF.Kaufmann UnitedStatesPublicHealth Service,StoneMountain,GA,UnitedStates
PaulKeim ThePathogenandMicrobiomeInstitute, NorthernArizonaUniversity,Flagstaff,AZ,United States
TerryL.Kerns Bio-LogicSecurity,LLC,LasVegas, NV,UnitedStates
AliS.Khan CollegeofPublicHealth,Universityof NebraskaMedicalCenter,Omaha,NE,United States
RachelE.Kieser CenterforHumanIdentification, GraduateSchoolofBiomedicalSciences,University ofNorthTexasHealthScienceCenter,FortWorth, TX,UnitedStates
RobKnight DepartmentofPediatrics,Department ofComputerScienceandEngineering,Microbiome InnovationCenter,UniversityofCalifornia,San Diego,CA,UnitedStates
AsjaKorajkic U.S.EnvironmentalProtection Agency,OfficeofResearchandDevelopment, Cincinnati,OH,UnitedStates
StevenB.Lee InternationalForensicResearchInstitute,FloridaInternationalUniversity,Miami,FL, UnitedStates;ForensicScienceProgram,DepartmentofJusticeStudies,SanJoseStateUniversity, SanJose,CA,UnitedStates
AnastasiaP.Litvintseva MycoticDiseasesBranch, CentersforDiseaseControlandPrevention, Atlanta,GA,UnitedStates
DouglasG.Luster USDAARS,ForeignDiseaseWeedScienceResearchUnit,FortDetrick,MD, UnitedStates
AaronLynne DepartmentofBiologicalSciences, SamHoustonStateUniversity,Huntsville,TX, UnitedStates
LeonardW.Mayer PanAmericanBioinformatics Institute,Cali,ValledelCauca,Colombia;Applied BioinformaticsLaboratory,Atlanta,GA,United States
UlrichMelcher OklahomaStateUniversity,DepartmentofBiochemistry & MolecularBiology,Stillwater,OK,UnitedStates
EricD.Merkley PacificNorthwestNationalLaboratory,Richland,WA,UnitedStates
JessicaL.Metcalf AnimalSciences,ColoradoState University,FortCollins,CO,UnitedStates
DeEttaK.Mills InternationalForensicResearch Institute,FloridaInternationalUniversity,Miami, FL,UnitedStates
StephenA.Morse IHRC,Inc.,Atlanta,GA,United States
TedD.Mullins AmericanTypeCultureCollection (ATCC),Manassas,VA,UnitedStates
RandallMurch VirginiaPolytechnicInstituteand StateUniversity,Arlington,VA,UnitedStates
ForrestW.Nutter,Jr. IowaStateUniversity,DepartmentofPlantPathologyandMicrobiology,Ames, IA,UnitedStates
FranciscoM.OchoaCorona DepartmentofEntomology & PlantPathology,NationalInstitutefor MicrobialForensics & FoodandAgriculturalBiosecurity,OklahomaStateUniversity,Stillwater, OK,UnitedStates
SamOgden AnimalSciences,ColoradoStateUniversity,FortCollins,CO,UnitedStates
RichardT.Okinaka ThePathogenandMicrobiome Institute,NorthernArizonaUniversity,Flagstaff, AZ,UnitedStates
TalimaPearson ThePathogenandMicrobiome Institute,NorthernArizonaUniversity,Flagstaff, AZ,UnitedStates
BernardR.Quigley IHRC,Inc.,Atlanta,GA,United States
LavanyaRishishwar SchoolofBiologicalSciences, GeorgiaInstituteofTechnology,Atlanta,GA, UnitedStates;PanAmericanBioinformaticsInstitute,Cali,ValledelCauca,Colombia;Applied BioinformaticsLaboratory,Atlanta,GA,United States
JasonW.Sahl ThePathogenandMicrobiomeInstitute,NorthernArizonaUniversity,Flagstaff,AZ, UnitedStates
StephenA.Saltzburg WallaceandBeverleyUniversityProfessor,TheGeorgeWashingtonUniversity LawSchool,UnitedStates
HaraldScherm UniversityofGeorgia,Department ofPlantPathology,Athens,GA,UnitedStates
DavidG.Schmale,III VirginiaTechUniversity, SchoolofPlantandEnvironmentalSciences,Blacksburg,VA,UnitedStates
SarahE.Schmedes AssociationofPublicHealth Laboratories,SilverSpring,MD,UnitedStates
StevenE.Schutzer DepartmentofMedicine, RutgersNewJerseyMedicalSchool,Newark,NJ, UnitedStates
OrinC.Shanks U.S.EnvironmentalProtection Agency,OfficeofResearchandDevelopment, Cincinnati,OH,UnitedStates
FrankP.Simione AmericanTypeCultureCollection(ATCC),Manassas,VA,UnitedStates
TomSlezak LawrenceLivermoreNationalLaboratory,Livermore,CA,UnitedStates
JeniferA.L.Smith DistrictofColumbiaDepartment ofForensicSciences,Washington,DC,UnitedStates
CarlaS.Thomas UniversityofCalifornia,Plant PathologyDepartment,Davis,CA,UnitedStates
StephanP.Velsko LawrenceLivermoreNational Laboratory,Livermore,CA,UnitedStates
RichardR.Vines AmericanTypeCultureCollection (ATCC),Manassas,VA,UnitedStates
AmyVogler ThePathogenandMicrobiomeInstitute,NorthernArizonaUniversity,Flagstaff,AZ, UnitedStates
DavidM.Wagner ThePathogenandMicrobiome Institute,NorthernArizonaUniversity,Flagstaff, AZ,UnitedStates
KarenL.Wahl PacificNorthwestNationalLaboratory,Richland,WA,UnitedStates
CharlesH.Williamson ThePathogenandMicrobiomeInstitute,NorthernArizonaUniversity, Flagstaff,AZ,UnitedStates
MarkWilson MRWAnalytics,LLC,Fredericksburg,VA,UnitedStates
AugustWoerner CenterforHumanIdenti fication, UniversityofNorthTexasHealthScienceCenter, FortWorth,TX,UnitedStates;Departmentof Microbiology,ImmunologyandGenetics,UniversityofNorthTexasHealthScienceCenter,Fort Worth,TX,UnitedStates
DavidS.Wunschel PacificNorthwestNational Laboratory,Richland,WA,UnitedStates
Foreword Iamhonoredthattheauthorshaveaskedme tocontributetheforewordtothethirdeditionof MicrobialForensics. Myconnectiontothebook andtothe fieldingeneralwasasafacilitator ratherthanasaresearcher,anditwasinthe distantpast,20yearsago!
MicrobialForensics receivedinputanddirection inaseriesofmeetingsheldattheBanburyCenter, aconferencecenteratColdSpringHarborLaboratory.Indeed,somemeetingsheldattheBanbury,whichpredatetheemergenceofMicrobial Forensicsasaformalizeddiscipline,laidsome ofthegroundworkforthismust-neededforensic field.Banburyhasaninternationalreputationfor intensivediscussionmeetingswithfewerthan30 participantsoftopicsinthelifesciencesthat wouldbenefitfromcriticalreview,topicsthat arefrequentlycontroversialandofteninvolve issuesofpolicyaswellasscience.
In1999,SuzanneVernonandBillReevesof theCentersforDiseaseControl(CDC) approachedmeaboutameetingtobefunded byCDCtodiscusshowitwouldbepossibleto detectanddeveloptestsforunknownpathogens.CDCwasinterestedbecauseithadbeen proposedthatchronicfatiguesyndrome(CFS) wasaninfectiousdisease,butthepathogen detectiontechniquesusedbyCDC serology, culture,PCR hadfailedtoidentifyaninfectiousagentassociatedwithCFS.By1999,new techniqueswerecomingonline,andCDC wantedtoreviewhowthesemightbeusedto findnovelorpreviouslyuncharacterizedpathogensassociatedwithCFS.
Banburyalreadyhadheldaseriesofmeetings onwhatwasstilla “newlyemerged” disease, Lymedisease . The firstmeetingwasheldin 1991,onlynineyearsafterWillyBurgdorfer hadidenti fiedthepreviouslyunknownpathogen,thespirochete, Borreliaburgdorferi.Iput Suzanneintouchwiththeorganizersofthose meetings,SteveSchutzerandBenLuft,andthe threeorganizedtheApril2000meeting “StrategiesforDetectionandIdentificationofUnknown Pathogens.”
Theprimaryfocusofthismeetingwas health,andtheword “forensic” didnotappear. However,oneoftheparticipantswasRoger Breeze,thenwiththeUSDepartmentofAgriculture.Whilethetitleofthemeetingheorganized inOctober2000hadtheratherinnocuoustitle “TheChallengeofInfectiousDiseasesinthe 21stCentury,” hisviewofunrecognizedinfectiousdiseasewasquitedefinitelyforensic;the invitationreferredtotheneedforstrategiesto dealwithnewandemergingthreats “ ofwhich biologicalterrorismisthelatest.”
Finally,inNovember2002,Schutzerand BreezewithBruceBudowle(thenwiththeFBI LaboratoryinQuantico)organizedthe first “MicrobialForensics” meeting,followedbyadditionalfourmeetings.The finalmeetingin2010 wason “MicrobialForensicsintheEraofGenomics,” whichreviewedtechniquesforDNA sequencingandbioinformaticsthatwereunfathomablemereeightyearsearlier.
Despitetheseandotherdramaticadvancesin technology,itisnotsurprisingthatthesame
broadissuesremain,someofwhichareidentifiedintheauthors’ introduction,forexample, thedifferingneedsoftheworldsofpublichealth andforensics;thelatterrequiredmeetingthe legalstandardsforevidencethatmightbeused inthecourt.
Theauthorsrefertotheissueofwhethermicrobialforensicswillbecentralized,forexample, attheNationalBioforensicsAnalysisCenter,or becomedistributed.Ifthelatter,adequate resources grainingandinfrastructure willbe needed,butthismaybehardtojustifyfor whatonehopeswillberareevents.
Insomeways,Iamremindedoftheearly daysofforensicDNA fingerprinting.Thetechniquesandassociatedpopulationgeneticanalyseshadbeendevelopedinacademic laboratories,andthereweremanyobstaclesto beovercomebeforeDNA fingerprintingwas accepted.Itrequiredtrainingintechniquesand theory,aswellasanacceptancebythepublic, lawenforcement,anddefenseattorneys,before
itbecameapowerfultoolforthejusticesystem. IamproudtorecallthataBanburyCenter meetingin1988(attendedbyBruceBudowle) contributedtocementingthistechnologyasthe goldstandardoftheforensicsciences.
Finally,Ifullyendorsetheauthors’ closing remarks.Scientificevidencecarriesgreatauthorityoverandaboveitsevidentiaryvalue.This responsibilityrequiresthatthoseemploying scientifictechniquesintheserviceofforensicsciencedosotothehigheststandardspossible.It tookseveralyearsforDNA fingerprintingto reachthatposition,anditwilltakethesame commitmentformicrobialforensicstoattain thesamelevelofcredibilityandacceptance. Butwithoutadoubt,itwillbewellworthwhile asthisburgeoningdisciplinecontinuestofulfill itspromise.
JanAWitkowskiPhD Professor ColdSpringHarborLaboratory
Introduction StephenA.Morse1,BruceBudowle2,StevenE.Schutzer3
1IHRC,Inc.,Atlanta,GA,UnitedStates; 2CenterforHumanIdenti fication,UniversityofNorthTexas HealthSciencesCenter,FortWorth,TX,UnitedStates; 3DepartmentofMedicine,RutgersNewJersey MedicalSchool,Newark,NJ,UnitedStates
Deliberatedisseminationofabiologicalagent viaseveraldifferentroutes,includingair,water, food,infectedvectors,andmanmadeavenues, presentsachallengetoglobalhealthandsecurity.Theabilitytoidentifytheperpetrator(s)in anexpeditiousandeffectivemannerisofparamountimportanceasbothadeterrentandfor gauginganappropriateresponse.Eliminating thoseindividualswhoarefalselyassociated withevidenceoracrimeisofequalimportance.
Thepastdecadehasseenmajoradvancesin thescienti ficdisciplineofmicrobialforensics, whosecoreobjectiveisattribution:theinvestigativeprocessaimedatidentifyingtheperpetratorsofabiowarfare,bioterrorism,or biocrimeeventandbringingthemtojustice. Thishighlyinterdisciplinary field,whichhas largelyemergedthroughUSinitiatives(Tucker andKoblentz,2009;U.S.,2010),encompasses traditionallawenforcementandforensicinvestigativemethodsaswellasthedetailedcharacterizationofsamplescontainingbiologicalagents. Moreover,withtheadventofhighthroughput technologies,suchasmassivelyparallel sequencing,microbialforensicsasadiscipline hasexpandedbeyonditsprimaryfocuson microbesandtheirproductsinvolvedinbioterrorismandbiocrimestootherapplicationssuch asexploitingthehumanmicrobiomeforhuman identification,humangeolocation,anddeterminingpostmorteminterval.
Microbialforensicinvestigationsandmolecularepidemiologicinvestigationssharemany aspectsbutareperformedfordifferentreasons. Anepidemiologicinvestigationaimstoidentify thesourceofanoutbreakandtounderstand routesoftransmissioninordertopreventfurther spreadandreducetheriskoffutureoutbreaks througheffectivepreventivemeasures.Amicrobialforensicinvestigationisundertakentoidentifytheperpetratorofacrimeandtogatherhigh qualityevidencethatcanbeusedforindictment andconvictionofperpetratorsortohelpdecisionmakersprepareanappropriateresponse toanattack.Amicrobialforensicinvestigation hasbeendescribedasconsistingofthreeinterrelatedstages:identificationofthebiological agent(s)responsibleforanevent;characterizationoftheeventasintentional,unintentional (e.g.,duetonegligenceorcarelessness),ornaturallyoccurring;and,iftheeventisdeemed illegitimate(i.e.,intentionalorunintentional), attributionofusetoaspeci ficperpetrator(s) (KoblentzandTucker,2010).Additionally, analysesmaybeusedtodeterminetheprocess(es)usedtoproduceabioweapon,which canprovideadditionalforensicevidenceand insightintothesophisticationoftheproduction process.Regardlessifaneventwasintentional oraccidental,animmediategoalistoprevent additionalattacksandprotectthepublic.
Manyofthequestionsaskedduringthe first twostagesofamicrobialforensicinvestigation areidenticaltothoseofanepidemiologicinvestigation,andthesamemethodsandtechnologies aregenerallyusedtoanswerthem(Sjodinetal., 2013).However,theattributionstepisuniqueto microbialforensics.Inadditiontotraditional forensicanalysesofrecoveredevidencefrom thecrimescene(analysisofhumanDNA, fingerprints, fibers,etc.),detailedanalysesareconductedoftheresponsiblebiologicagent (bacterium,virus,fungus,ortoxin).Itispossible thattheresultsofanepidemiologicinvestigation maysuggestadeliberateorunintentionalrelease ofabiologicalagentandthusleadtotheinitiationofamicrobialforensicinvestigation.The intentionalreleaseofabiologicalagentcanbe doneovertly,inwhichcasetheperpetrators willannouncetheirresponsibility,orcovertly, inwhichcasetheywillnotcallattentiontothe releaseofabiologicalagent(Budowleetal., 2005).Itislikelythatmostunintentionalreleases willbecovert-likeinnature(ZimmerandBurke, 2009).
Sincethepublicationofthe firsteditionofthis bookin2005,the fieldofmicrobialforensicshas evolvedsubstantiallyinitsabilitytoattributethe sourceofmicroorganismsandtoxinsthathave beenusedincasesofbioterrorismandinbiocrimes.The2001anthraxmailattack(often referredtoas “Amerithrax”)fortunatelyremains theworstandbest-knownexampleofsuccessful bioterrorismonUSsoil(Chapters2and3).At thetime,theUSwasillpreparedtoinvestigate theuniquetypesofmicrobiologicalevidence forattributionthatweregeneratedbythatinvestigation,althoughtraditionaltypesofforensic evidencecouldreadilybecollected,analyzed, andinterpretedwithintheframeworkofastatisticallysoundscientificfoundation.The first editionofthisbookhadonlylimitedreference totheanthraxmailattackbecausemuchofthe scienti ficexaminationwasstillinprogressand methodologieswerestillunderdevelopment. Earlycapabilitieswereinitiallylimitedto
detectionandidentificationanddidnotinclude detailedcharacterizationandcomparativeanalyses.Thus,the firsteditionwasdevelopedasa foundationaltexttostimulatescientists,legal experts,anddecisionmakersresponsiblefor analyzingandinterpretingevidencefroman actofbiologicalwarfare,bioterrorism,biocrime, orinadvertentreleaseofamicroorganismor toxinforattributionpurposesandtodescribethe discipline.Inaddition,theinitialeditionofthis bookdiscussedsomeofthefutureopportunities andchallengesforthemicrobialforensic fi eld.
Thesecondeditionofthisbook,publishedin 2011,containedseveralchaptersthatbroughtthe Amerithraxinvestigationtoaconclusion.The anthraxmailinvestigation,oneofthemost intenseandexpansiveinvestigationstodateby theFederalBureauofInvestigationandUS PostalService(http://www.fbi.gov/antrhrax/ amerithraxlinks.htm),isnowconsideredclosed. However,thethirdeditionofthisbookrevisits thiscaseandprovidesa first-handaccountof theinvestigationaswellaslessonslearnedon whatshouldbedoneinmicrobialforensicsto supportaninvestigationandequallyimportant whatshouldbeavoided.
Manyoftheelementsdiscussedinthe first andsecondeditionsofthisbookareechoedin the2009USNationalResearchandDevelopmentStrategyforMicrobialForensics(U.S., 2010),whichidentifiesthreatawareness,preventionandprotection,surveillanceanddetection, andresponseandrecoveryastheessentialpillarsofUSnationalbiodefensepolicy. “Attribution” theinvestigativeprocessby whichtheUSgovernmentlinkstheidentityof aperpetratororperpetratorsofillicitactivity andthepathwayleadingtocriminalactivity is partofthesurveillanceanddetectionpillar. Makingadeterminationofattributionfora plannedoractualperpetratedbiologicalattack wouldbetheculminationofacomplexinvestigativeprocessdrawingonmanydifferentsourcesofinformation,includingtraditional forensicanalysisofmaterialevidencecollected
duringaninvestigationofaplannedattackor materialevidenceresultingfromanattackand relevantsubjectmatterexperts.Oneofthekey sourcesofattributioninformationinabiological attackistheresultofamicrobialforensic investigation.
Futureinvestigationsofbiologicalwarfare, bioterrorismevents,orbiocrimesarelikelyto beasmultifacetedastheAmerithraxinvestigation,ifnotmoreso,andwilldemandmoreintegrationandbettercommunicationamong governmentagencies.Fortunately,thetechnologiestodayprovidemuchbettercapabilitiesto respondwithastrongmicrobialforensicprogram.Atthesametime,microbialforensicsis stilladeveloping fieldfacingnumerousscientific challenges.Fortheseandotherreasons,governmentsaremakinginvestments,oftenforpublic healthpurposes,toprovidearobustcapability todetect,identify,andcharacterizebiological agents.Advancesinthisareahavebeensuf ficientlyexcitingandsignificanttomakethisthird editionof MicrobialForensics bothtimelyand necessary.Thereisgrowinginterestandapplicationofmicrobialforensicprinciplesinfood safety,waterquality,andbioinformatics,and thusthiseditioncontainschapterstocovera broaderaudienceinterestthanthatofnational security.Werecognizethattraditionaldetective investigation,coupledwithscientificanalysis ofevidenceandfrequentlyadditionalongoing andnovelexperimentation,cangenerateinvestigativeleads.Thus,chaptersonmicrobial forensicapproachestohumanidentification andthedeterminationofpostmorteminterval havebeenincluded.
The firsteditionofthisbookwasdeveloped forindividualsenteringthe fieldofmicrobialforensicswhowerelookingforasinglesourcefor initialguidanceandinformation.Thesecond editionsupportedthatneedwithacombination ofbasictextsandchaptersonmoresophisticated technologies,suchasnonbiologicalanalytical toolsandnext-generationsequencingmethods. Therapidadvanceintechnologyandits
applicationhaveledtothethirdedition.This editionrecognizesthecombinationofdiverse disciplinesthatmustbeexploitedtoanalyzeevidence,includingbiology,microbiology,medicine,chemistry,physics,statistics,population genetics,computerscience,andcomputational biology.Newtechniquesmustbedeveloped andemployedtoextractthemostinformation fromforensicevidenceobtainedfromterrorist andcriminalevents,especiallywhenmoretraditionalformsofevidenceareeithernotavailable orverylimitedincontent.Yetmicrobial forensics amaturingdiscipline depends veryheavilyonsometraditionalandfrequently overlookedscienti ficvalues:willingnesstoshare oftenpricelesssampleswithothersacrossinternationalboundaries,rigorouscurationofmicrobialrepositorysamplesoverdecades,and organizationandexecutionofinternational collaborativestudieswithrecognitionofall involved.
Overthepastcentury,sciencehasplayedan increasinglygreaterroleincriminalinvestigation(Budowleetal.,2008,2009).Microbial forensicsciencewillcontinuethistradition.But scientificanalysisisonlypartoftheprocess. Forensicscienceresultsmustbeintegratedwith otherinformation,andattentionmustbepaid tostepsthatwillassurethequalityofresultsas wellassupporttheiradmissibilityinacourtof law(seeChapter23 27).Westressqualitycontrolandqualityassuranceasthemeanstoensure integrityoftheevidence.Practicessuchasadherencetochainofcustodyprocedures,documentationofactivities,andtheuseofvalidated reagents,calibratedequipment,negativeand knownpositivecontrolsamples,validatedprocedures,standardoperatingprocedures,andso onaretheessenceofreliabilityandconfidence. Thesecriteriainturnensureadmissibilityin court.
Thescienti ficfoundationsofmicrobialforensicswillbestrengthened,builtupon,andlikely remodeledbyourpresentandfuturecolleagues. Theiraccomplishmentsoverthepasteightyears
haveledtothisnewedition.Welookforwardto theircontinuedinput,interaction,andinsight.
References Budowle,B.,Bottrell,M.C.,Bunch,S.G.,Fram,R., Harrison,D.,Meagher,S.,etal.,2009.Aperspectiveonerrors,bias,andinterpretationintheforensicsciencesand directionforcontinuingadvancement.J.ForensicSci. 54,798 809.
Budowle,B.,Schutzer,S.E.,Ascher,M.S.,Atlas,R.M., Burans,J.P.,Chakraborty,R.,etal.,2005.Towardasystemofmicrobialforensics:fromsamplecollectiontointerpretationofevidence.Appl.Environ.Microbiol.71, 2209 2213.
Budowle,B.,Schutzer,S.E.,Morse,S.A.,Martinez,K.F., Chakraborty,R.,Marrone,B.L.,etal.,2008.Criteriafor validationofmethodsinmicrobialforensics.Appl.Environ.Microbiol.74,5599 5607.
Koblentz,G.D.,Tucker,J.B.,2010.Tracinganattack:the promiseandpitfallsofmicrobialforensics.Survival52, 159 186.
Sjodin,A.,Broman,T.,Melefors,O.,Andersson,G., Rasmusson,B.,Knutsson,R.,etal.,2013.Theneedfor high-qualitywhole-genomesequencedatabasesinmicrobialforemsics.Biosec.Bioterror.11(Suppl.1),S78 S86. Tucker,J.B.,Koblentz,G.D.,2009.Thefourfacesofmicrobial forensics.Biosecur.Bioterror.7,389 397. U.S.,2010.NationalScienceandTechnologyCouncil,ExecutiveOfficeofthePresident,NationalResearchandDevelopmentStrategyforMicrobialForensics. http:www.white house.gov/ fi les/documents/ostp/NSTC%20Reports/ National%20MicroForensics%20R &DStrategy%202009 %20UNLIMITED%20DISTRIBUTION.pdf . Zimmer,S.M.,Burke,D.S.,2009.Historicalperspective emergenceofinfluenzaA(H1N1)viruses.NewEngl.J. Med.361,279 285.
TheKameidoanthraxincident:a microbialforensiccasestudy ArnoldF.Kaufmann1,PaulKeim2
1UnitedStatesPublicHealthService,StoneMountain,GA,UnitedStates; 2ThePathogenandMicrobiome Institute,NorthernArizonaUniversity,Flagstaff,AZ,UnitedStates
Introduction TheAumShinrikyo,anapocalypticreligious sectbasedinJapan, firstcametoworldwideattentionin1995astheresultoftheirdeadlysaringas attackontheTokyosubwaysystem(Hudson, 1999;Smithson,2000;Tu,2002).Subsequent investigationsrevealedthattheAumShinrikyo hadlaunchedearlierattackswithbothchemical andbiologicalagents.Thebiologicalattacksutilizing Bacillusanthracis sporesandbotulinum neurotoxinwerenotablyunsuccessful,withfailuretoproduceanycasualtiesinatleastseven allegedattemptsoverseveralyearsbeginningin 1990.Inthischapter,anattackin1993thatwas launchedfromtheAumShinrikyoheadquarters buildingthenlocatedinKameido,aTokyosuburb,willbediscussed,withemphasisonlaboratoryandepidemiologicalstudies(Takahashi etal.,2004;Keimetal.,2001).
TheAumShinrikyo:abriefhistory ToputtheKameidoincidentintocontext,a briefhistoryoftheAumShinrikyoanditsfounder,
primarilyadaptedfromthereviewsbyHudson, Smithson,andTu,isuseful(Hudson,1999; Smithson,2000;Tu,2002).TheAumShinrikyo wasfoundedbyShokoAsahara,whosebirth namewasChizuoMatsumoto.Bornintopoverty in1955andsufferingseverevisualimpairment duetoinfantileglaucoma,Matsumotowassent atayoungagetoagovernment-subsidized boardingschoolfortheblind.Hepurportedly feltabandonedbyhisfamily,whichmayhave laterledtoanAumShinrikyorulethatfollowers weretocutoffrelationshipswiththeirparentsto attainthesupremetruth.
Havinglimitedvisioninoneeye,Matsumoto developedinfluenceovertheotherblindstudents,whopaidhimforvariousservices.During hisstudentyears,hedevelopedareputationasa bullyandconartist.Afterhighschoolgraduation in1975,Matsumotoestablishedasuccessful acupunctureclinic,buthehadtomovetoTokyo in1977duetohisinvolvementina fightthat resultedininjurytoseveralpersons.Aboutthis time,hisstatedambitionsincludedbecoming theleaderofarobotkingdomorthePrime MinisterofJapan.
InTokyo,hefoundworkasanacupuncturist andenrolledinapreparatoryschoolfortheJapanesecollegeentranceexamination,withagoal ofqualifyingformatriculationinTokyoUniversity.Failingtheentranceexamination,Matsumotomarriedandestablishedanacupuncture clinicandanaturalfoodsshop.Asasideline, heconcoctedanalcoholextractoftangerine skinsthathemarketedasamiracledrugfor weightlossandavarietyofotherconditions. Hissuccessinsalesofthisproductattracted theattentionofthepoliceandsubsequentarrest andimprisonmentforviolatingtheJapanese CosmeticsandMedicalInstrumentsAct.This experiencemayhavecontributedtohisanimositytowardestablishedauthority.
AfterhismovetoTokyo,Matsumotobecame interestedinreligionand,in1981,joinedAgon Shu,anewreligionbasedonBuddhismand yoga.In1984,MatsumotoquittheAgonShu andestablishedAumShinsen,ayogaclubwhich rapidlygrewfrom15tomorethan1000 members.HealsochangedhisnametoShoko AsaharaorBrightLightinJapanese.Following atriptoIndiain1986 87,Asaharachangedthe nameoftheyogaclubtoAumShinrikyo.Aum isaHindusyllablerepresentingthespoken essenceoftheuniverse,andShinrikyoisderived fromtheJapanesewordsfor “supremetruth.” In 1989,AumShinrikyowasofficiallyrecognizedas areligioussectinJapan,givingthesecttax advantagesaswellastheabilitytoclaimthe members’ workinthesect’svariousenterprises asvoluntary.Thesect’sgrowthcontinuedwith spreadtoothercountries,includingtheUnited States,Germany,andRussia.
SectmemberslivedaSpartanlifeandwereexpectedtocutoffallassociationsfromtheirpast life,totakeachastityvow,andtoturnoverall theirassetstotheAumShinrikyo.Theyweresubjectedtoaheavydietoftheirmaster’ s “wisdom,” oftensimultaneouslyundergoingfoodandsleep deprivation.Memberswereexpectedtovoluntarilylaborinthesect’svariouscommercialenterprises,suchassalesofherbalteasandnatural
medications,operationofnoodleshops,health clubsandbaby-sittingservices,andcomputerrelatedservices.Thosewhobalkedweredriven everharder,druggedandconfined.Insome extremecases,defectorsweremurdered.
Tocarryoutitsactivities,theAumShinrikyo developedacomplexorganizationalstructure consistingof22ministriesplustheOfficesofReligiousMembers.Thelatterwaschargedwith recruitmentofpersonshavingneededskills, suchasmembersoftheJapaneseSelfDefense Forcesandscientists.Ineffect,theAumShinrikyo assumedtheformofashadowgovernment whichcouldsupplanttheexistentJapanesegovernmentifAsahara’sambitionswerefulfilled.
By1990,withmembershipinthetensofthousandsspreadoversixcountriesandanestimated 300milliontoabilliondollarsavailable,the AumShinrikyowaswellpositionedtofurther Asahara’sambitionsanddelusions.TheAum Shinrikyoinitiallyattemptedaconventional approachtopoliticalpowerby fieldingaslate of25candidatesforthenationalelectionsthat year.Noneofthecandidates,includingAsahara, wereevenmodestlysuccessful.Asahara believedthattheJapanesegovernmenthad cheatedhimratherthanthattheelectoratewas putoffbythedoomsdayovertonesofthecandidate’sspeeches.Hisbeliefwasreinforcedbythe factthatthenumberofvotesreceivedbyall thecandidateswasfarfewerthanthenumber ofAumShinrikyomembersinJapan.
Basedonapasticheofapocalypticscenarios drawnfromvariousreligions,Asaharapreached thatJapanwasdestinedtosufferanumberof overwhelmingcatastrophes,includingapoison gasattackbytheUnitedStates.Asaharaand hisfollowerswouldsurvivetheloomingArmageddonandevolveintoasuperracedominating theworld.Hebecamemorevocalinexpressing thisbeliefafterthehumiliatingelectoraldefeat in1990.Notcontenttoallowthecatastrophes tooccurintheirowntime,Asaharainitiated developmentofchemicalandbiological weaponstospeeduptheprocess.
Onlythechemicalweaponsprogramhad somesuccess.Afterovercominginitialproductionproblems,theAumlaunchedanattack withsaringasinMatsumotoCityinJune1994. Theattacktargetedjudgespresidingoveraland usedisputebetweentheAumShinrikyoanda localrealestateagent.Suspectingthatthejudges wouldmakeadecisionunfavorabletothecult, Asaharaorderedtheirassassination.Thisgave anopportunitytotesttheeffectivenessoftheir sarinonhumans.Thesarinreleaseutilizeda spraydeviceandresultedin311knowncasualties,with58hospitalized,including7deaths. Thejudgeswereunharmed.
InvestigationoftheMatsumotoCityattack proceededslowly,withoutdefinitiveevidence linkingthecrimetoaspeci ficindividualor group.TheAumShinrikyowassuspected,and asarindegradationproductwasdetectedin soilnearabuildinginanAumShinrikyocompound,theSeventhSatayan,inKamakiuishiki. Thepolicedidnotseekawarranttosearchthe facilitybecauseofaconservativeinterpretation ofpertinentlaws.Inanunrelatedkidnapping case,however,thepolicefound fingerprintevidencethatanAumShinrikyomemberwas involved.Thisgaveajusti ficationforobtaining awarranttoinvestigatethefacility.InMarch 1995,Asaharalearnedoftheplansforapolice raidfromAummemberswithintheJapanese SelfDefenseForces.Inaploytodistractthe policeandbuytime,Asaharadecidedtorelease sarinintheTokyosubwaysystem.Twodays later,theattackwascarriedout,resultingin severalthousandcasualties,including12fatalities.Duringthesameperiod(1994 95)they alsoproduced100 200gofVX,whichwas usedtoattackthreepersons(onedied).Hence, theAum’schemicalweaponsprogramwas moreextensivethansarin.
TheAumShinrikyoculthadbeenthoughtto beanoddgroupandevenanuisanceonoccasion.InvestigationsaftertheTokyosarinattack revealedamoresinisteraspectofthesectand itsleader.Inadditiontothechemicalweapons
developmentprogram,theAumShinrikyowas foundtohavebeenactivelypursuingbiological weapons,albeitwithoutsuccessduetoincompetence.Inparticular,theineffectivereleaseof B.anthracis sporesinKameidowasdiscovered, leadingtotheinvestigationsdiscussedinthis chapter.
TheKameidoanthraxincident OnJune29 30,1993,complaintsaboutfoul odorswereregisteredwithlocalenvironmental healthauthoritiesinKameidointheTokyo metropolitanarea(Takahashietal.,2004).The odorsoriginatedfromtheeight-storyheadquartersbuildingoftheAumShinrikyo.Someofthe exposedpersonsreportedappetiteloss,nausea, andvomiting.Birdsandpetswerealsoreportedlyill,butthenatureoftheseillnesseswasnot defined.Theenvironmentalhealthofficials requestedpermissiontoinspecttheheadquarters building,butAumShinrikyomembersatthe scenerefused.Theofficialscheckedthebuilding’ s exterior,collectedairsamples,andbegansurveillanceofactivitiesatthebuilding.Otherthanthe nuisanceposedbytheodor,definitivehuman healthriskscouldnotbeidentified.
OnthemorningofJuly1,neighborsbeganto complainaboutloudnoisesandanintermittent mistoriginatingfromoneoftwostructureson theroofwhichwerethoughttobecoolingtowers (Fig.1.1).Asthedayprogressed,118complaints aboutfoulodorswerereceivedfromnearbyresidents,primarilytothesouthofthebuilding. Winds(2 4m/s)thatdayblewfromanortheasterlydirection(Takahashietal.,2004).Lightrain (7mmtotal)fellintheearlymorning,withcloudy conditionsthereafter.Thetemperatureranged from16.9to19.9 Cthroughtheday.
A “gelatin-like,oily,gray-to-black” fluidfrom themistcomingoffthe “coolingtowers ” collectedonthesideofthebuilding(Takahashi etal.,2004).Samplesofthe fluidwerecollected bytheenvironmentalhealthofficialsandstored inarefrigerator(4 C)forlatertesting.
FIGURE1.1 MistbeingdispersedfromspraydeviceontheroofoftheAumShinrikyoheadquartersbuilding,Kameido, Japan,July1,2006(Takahashietal.,2004).
Thenextday,July2,ShokoAsaharaagreedto stopusingtherooftopdevicesandtocleanand vacatethebuilding(Takahashietal.,2004).An environmentalinspectionfoundnoequipment, includingtherooftopdevices,remaininginthe building,andblackstainsonthewallswere theonlynotableobservation.
Theproblem,apparentlybeingresolved,was largelyforgottenuntil1996.Policeinvestigations ofthesarinattackontheTokyosubwaysystem revealedthattheAumShinrikyowasalso involvedinbioterrorism.FollowingtheconservativeJapanesepolicyofnotrevealingcriminal evidenceuntilthetimeoftrialincourt,thetruenatureoftheKameidoincidentwas firstdisclosedto thepublicinMay1996whenAsaharawas arraigned(Smithson,2000;Takahashietal., 2004).AumShinrikyomembershadconfessed thattheodorsresultedfromeffortstoaerosolize aliquidsuspensionof B.anthracis spores.The motivewastotriggeraninhalationalanthrax epidemicandasubsequentworldwar.The warwouldculminateintheAumShinrikyo membersbecomingasuperracewhichwould ruletheworldinaccordwithAsahara’spreaching(Takahashietal.,2004).
Manyquestionsabouttheincidentremained unanswered.Forexample,didtheattackactually occur?Ifso,were B.anthracis sporesutilized? Couldthespecific B.anthracis strainanditsorigin beidentified?Wasthestrainvirulent?Whydid theattackapparentlyfail?Hadillnessesoccurred butgoneundetected?Investigationswereinitiatedtobettercharacterizetheallegedattackand itsconsequences.
Microbialforensicinvestigation Fluid,thathadbeencollectedfromtheAum ShinrikyoheadquartersbuildinginJuly1993 andsubsequentlystoredat4 C,wasexamined inJanuary2000forbacterialcontent(Keim etal.,2001).Polymerasechainreaction(PCR) screeningofthe fluidwaspositivefor B.anthracis.Microscopicexaminationofthe fluid afterstainingwithmalachitegreenandsafranin revealedspores,nonspecificdebris,andbacterial cellsotherthanlargebacilli.The fluidwas culturedbyspreadingonsheepbloodagarplates andincubatingat37 CunderambientCO2 concentration(Fig.1.2).Basedonthenumberof
bacterialcoloniesobservedontheplatesafterincubation,the fluidcontainedapproximately 4 104 bacterialcolony-formingunits(CFUs) permL.Mostcoloniesgrewonlyweaklyand weremorphologicallyinconsistentwithnormal B.anthracis characteristicswhengrownunder theseconditions.Thepoorlygrowingbacteria werenotfurthercharacterized.
About10%ofthecoloniesontheplateswere typicalof B.anthracis ,beinglargeandhavinga nonhemolytic, “graygroundglass” appearance (Fig.1.2).Thenumberofobservedcolonies consistentwith B.anthracis wasconsistentwith aconcentrationof4 103 CFUpermLofthe fluid.Forty-eightofthesecolonieswerepurified bysingle-colonystreakingandsubjectedtothe 8-locusmultiple-locusvariable-numbertandem repeatanalysis(MLVA)(Keimetal.,2000).All 48colonieswere B.anthracis andhadanidentical MLVAgenotype,thoughtheVNTRmarkeron thepX02plasmidfailedtoamplify.Thegenotype ofall48strainswasvrrA,313bp;vrrB1,229bp; vrrB2,162bp;vrrC1;583bp;vrrC2;532bp;CG3, 158bp;pX01-aat,129bp;pX02-at,noamplification.ThelackofPCRamplificationatthepX02 markersisconsistentwithstrainsthataremissing
thepX02plasmidentirely.Amplificationofthese locicanoccurincloselyrelated Bacilluscereus strains,buttheactualampliconsizeshadbeen previouslyobservedonlyin B.anthracis.The MLVAgenotypeobservedwasconsistentwith resultsobtainedwiththeSterneanthraxvaccine strain(Fig.1.3).TheSternestrainisamemberof theA3.bdiversitycluster,andinastudyof419 isolatesonlyfournaturallyoccurring B.anthracis strainsintheelectronicdatabaseofworldwide isolateshadthesameseven-markergenotype, thoughthesestrainswerepX02positive(Keim etal.,2000).
Astheabilitytoperformwholegenome sequencinghasimproved,oneisolatecollected
FIGURE1.3 Multiple-locus,variable-numbertandem repeatanalysisofaKameidoisolateandtheSternestrainof Bacillusanthracis (Takahashietal.,2004).
FIGURE1.2 Bloodagarplateofthesamplingfromthe Kameidosite(Takahashietal.,2004).
atthereleasesitewasDNAsequencedusing shortreadIlluminatechnology(Keim,unpublisheddata).TheresultingsequencewasidenticaltothatoftheSternegenomeavailableat NCBI.Thissuggeststhatthecultdirectlyused acommercialstockwithoutmanipulationor extensivelaboratorygrowth.
TheSterne34F2 anthraxvaccinestrainis commerciallyavailableinJapanforveterinary use.Ithadbeenpreviouslyreportedthatthe AumShinrikyohadobtainedaveterinaryvaccinestrainof B.anthracis whichmayhavebeen usedbythemforbioterroristattacks(Hudson, 1999).Ourresultsareconsistentwiththispreviouslyunsubstantiatedreport.TheSternestrain haslowvirulenceduetolackofthepXO2 plasmid,whichisthelocationofgenescoding forthepoly-D-glutamatecapsule,amajorvirulencefactorof B.anthracis
Epidemiologicinvestigation Culture-con firmedanthraxisanationally notifiablediseaseinJapan,withphysiciansbeing requiredtoreportallcases(Takahashietal., 2004).Onlyfourhumananthraxcaseswere reportedduringthe1990s,withasinglecasebeingreportedinTokyo.TheTokyocasewasdiagnosedinamanwhowasinhiseightiesand residedinSumidawardwhichisadjacentto Kameidoward.ThecaseoccurredinAugust 1994andhadnoobviousassociationwiththe 1993Kameidoincident.
Couldadditionalanthraxcasesfromthe1993 attackhavegoneunrecognizedorunreported?A retrospectivecase-detectionsurveywasconductedin1999toaddressthisquestion(Takahashi etal.,2004).Usingtheofficialregistryof “foul odor” complaints,theresidencesofthe118complainantsweremappedtoidentifytheareaof presumedhighestrisk.The0.33km2 high-risk areadeterminedbythisapproachcontained approximately3400householdsand7000 residents.Atelephonesurveywasconductedof
physiciansat39medicalfacilities(15internal medicine,7dermatology,and15other specialties)servingthearea.Noneofthesephysicianshadtreatedcasesofanthrax,unexplained seriousrespiratoryillnesses,orhemorrhagicmeningitis,acommoncomplicationofsystemic anthraxinresidentsofthehigh-riskarea(Holty etal.,2006).
Discussion Severallessonscanbelearnedfromthe Kameidoincident.Theinvestigationsuffered fromafailuretodetecttheincidentatthetime. TheAumShinrikyodidnotattractmuchofficial attentionuntilthesarinattackinMatsumoto Cityin1994.TheJapanesecultureisverytolerant ofvaryingreligiousbeliefs,anattitudereflecting Japaneseconstitutionalguaranteesofreligious freedom.TheAumShinrikyowasbutoneof morethan180,000minorreligionsactiveinJapan (Hudson,1999).Thepolicepolicyofconservative interpretationofpertinentlawswasanotherfactor.Inaddition,thepolicyofnotrevealingdetails aboutacriminalinvestigationuntilthetimecourt proceduresareinitiatedslowedcommunications betweenpertinentagencies,delayinginvestigationevenaftertheAumShinrikyo’sattemptto utilizebiologicweapons firstbecameknownduringtheinvestigationofthe1995sarinattackon theTokyosubway(Tu,2002).Awarenessof potentialthreats,alowthresholdofsuspicion, andactivesharingofinformationbetween governmentalagencieshavingpertinentexpertise and/orauthorityaresomekeycomponentsin earlydetectionofterrorismincidents.
EarlycharacterizationoftheAumShinrikyo biologicalweaponsprogramwasprimarily basedonstatementsbytheperpetratorsand expertopinions(Hudson,1999;Smithson,2000; Tu,2002).Physicalevidenceandindependent corroborationoftheclaimswerenotablyabsent. Fortunately,healthofficialshadcollectedaspecimenof fluidfromthebuildingatthetimeofthe
Kameidoincidentalthoughitwasnotbeen analyzedatthetime.The fluidwaskeptas potentialevidenceintheeventdiseasecouldbe associatedwiththeincident.Apolicyofkeeping evidenceforaperiodofyearsalloweditsexaminationin2000,morethan6yearsaftertheincident.Fromaforensicperspective,however,the lackofformalchain-of-custodydocumentation mightbeanissueinsomejurisdictions.
TheMLVAanalysisofthe B.anthracis strain isolatedfromthe fluidfromthebuildingrevealed agenotypeconsistentwiththatoftheSterne34F2 anthraxvaccinestrain.Adirectcomparison,however,wasnotmadewiththeSterne34F2 strain usedtoproduceanthraxvaccineinJapan.Inaddition,theMLVAgenotypicmatchwasnotunique toSterneasthepublisheddatabasecontained additionalsampleswithidentical(excluding pXO2)genotypes.NosamplesfromJapanhad everbeencharacterizedusingMLVAand,as such,thenaturalbackground B.anthracis was unknown.Asnotedabove,wholegenome sequencinghasbeenrecentlyperformedandthe exactidentitybetweentheKameidoisolateand thecommercialSternestraingenomestronglysupportsthepositionthatthisiswhatthecultused.In addition,noeffortwasmadetoisolate B.anthracis fromthebuilding’senvironmentoradjoining areasofKameidotoprovideevidencethatthe strainisolatedfromthe fluidhadbeendispersed andtheextentofthedispersal.Theabilityof B.anthracis tosurvivemanyyearsincontaminated environmentmakessuchaneffortpotentiallyproductive(Turnbull,2008).
Whydidnodiseaseresultfromtheattack? Onepossibilityisasmallinhaleddoseofspores forexposedpersons.Althoughpresumably straindependent,theminimuminhaleddosage capableofcausinghumandiseaseisunclear. However,unknownssuchasaerosoldispersal deviceefficiencyingeneratinga fineparticle aerosol,concentrationofsporesinthe fluidbeing dispersed,andaerosolcloudmovementprecludemakingdefensibleestimatesofinhaled dosageforpersonsexposedduringtheattack.
AnotherpossiblefactorinlackofdetecteddiseaseisthelowvirulenceoftheSternestrainfor humans.Despitefrequentaccidentalinoculationsofthevaccineduringimmunizationof domesticanimals,nodocumentedcasesofassociateddiseasehavebeenreported.TheSterne strainlacksacapsule,andotherstrainsof B.anthracis lackingacapsulerarelyproduce humanillness.Onlythreereportsofillnessassociatedwithnonencapsulatedstrainshavebeen made,withonecasebeinginanimmunocompromisedpersonandthecause effectrelationshipoftheisolatetotheillnessobservedinthe othertwocasesbeinguncertain.
Serologicstudieswerenotdoneatthetimeof theeventbutcouldhavebeenpotentiallyuseful. Forexample,antibodyandcell-mediatedimmuneresponsesinpersonswhowereexposed inthe2001bioterrorismattackattheUnited Statescapitolwereusedtodemonstrateinfection withoutresultantdisease(Doolanetal.,2007).If asimilarstudyhadbeendoneinKameidoatthe timeoftheattack,thequestionofwhetherinfectionhadoccurredinabsenceofdiseasecould havebeenaddressed.ThelonglapseoftimebetweentheKameidoeventandtheepidemiologic studywouldcompromisethevalidityofsuch studiesatthistime.
Theisolationof B.anthracis andtheresultsof theMLVAtestingmighthaveprovenusefulin prosecutingsomeAumShinrikyomembers, butthiswillhavetoremainconjectural.Criminal chargesrelatedtothebiologicweaponsdevelopmentandattackswerenotmade,and,hence,the microbiologicalevidencewasnevertestedin court.However,13AumShinrikyomembers, includingAsahara,havebeenconvictedfor perpetratingthesarinattackontheTokyosubwayandcondemnedtodeath.Threeofthe AumShinrrikyomembersincludingAsahara wereexecutedbyhangingin2018afterappeals hadbeenexhaustedforalloftheaccused.
Despitetheconvictionsofmanyleaders,the AumShinrikyocontinuestoexist,havingbeen renamedAleph,the firstletterofthePhoenician
alphabet.Asplintergroup,HikarinoWaorRing ofLight,brokeofffromAlephfollowingdiscord withintheAlephleadership.Surveillanceofthe twogroupsforpotentialterroristactivitieshas beenmaintained,andtheyhavebeenformally designatedterroristorganizationsbyseveral countries,includingtheEuropeanUnion,Russia, Canada,Kazakhstan,andtheUnitedStates.
Challenges TheKameidoincidentunderscoredanumber ofessentialconceptsinmicrobialforensics.Implementingtheseconceptsmustbeahighpriority forlawenforcementjurisdictions.Earlycommunicationandinformationsharingbetweenappropriategovernmentalagencies,particularlylaw enforcementandpublichealth,areessentialto anoptimaloutcomeofmicrobialforensicstudies. Publichealthagencieshaveamajorroleinthe investigationofsuspectedanddocumentedbioterrorismincidents,butthesimilaritiesanddifferencesinpublichealthandlawenforcement investigationsmustbeunderstoodandcoordinatedsothatbothcanbemoreeffective(Butler etal.,2002).Investigationsmust,ofnecessity,be multidisciplinaryanddrawonthebestavailable expertisewhetherornotlocatedinagovernmentalagency.Specimentestingmustfollow establishedchain-of-custodyprocedures,andall involvedgroupsmustbetrainedintheseprocedures.Strainsubtypingisapowerfulinvestigative toolfortracingtheoriginsofmicrobialagents,but theproceduresmustbevalidatedandhaveyetto beacceptedbythecourts.Epidemiologicstudies areessentialtoputtinglaboratory findingsinto thecontextofabioterroristevent.
References Butler,J.C.,Cohen,M.L.,Friedman,C.R.,Scripp,R.M., Watz,C.G.,2002.Collaborationbetweenpublichealth andlawenforcement:newparadigmsandpartnerships forbioterrorismplanningandresponse.Emerg.Infect. Dis.8(10),1152 1156.
Doolan,D.L.,Freilich,D.A.,Brice,G.T.,Burgess,T.H., Berzins,M.P.,Bull,R.L.,Graber,N.L.,Dabbs,J.L., Shatney,L.L.,Blazes,D.L.,Bebris,L.M.,Malone,M.F., Eisold,J.F.,Mateczun,A.J.,Martin,G.J.,2007.TheUS capitolbioterrorismanthraxexposures:clinicalepidemiologicalandimmunologicalcharacteristics.J.Infect.Dis. 195(2),174 184.
Holty,J.E.C.,Bravata,D.M.,Liu,H.,Olshen,R.A., McDonald,K.M.,Owens,D.K.,2006.Systemicreview:a centuryofinhalationalanthraxcasesfrom1900to2005. Ann.Intern.Med.144(4),270 280.
Hudson,R.A.,1999.TheSociologyandPsychologyof Terrorism:WhoBecomesaTerroristandWhy?Library ofCongress,FederalResearchDivisionReportLibrary ofCongress,Washington,DC.
Keim,P.,Price,L.B.,Klevytska,Smith,K.L.,Schupp,J.M., Okinaka,R.,Jackson,P.,Hugh-Jones,M.E.,2000. Multiple-locusVNTRanalysis(MLVA)revealsgenetic relationshipswithin Bacillusanthracis.J.Bacteriol.182 (10),2928 2936.
Keim,P.,Smith,K.L.,Keys,C.,Takahashi,H.,Kurata,T., Kaufmann,A.,2001.Molecularinvestigationofthe AumShinrikyoanthraxreleaseinKameido,Japan. J.Clin.Microbiol.39(12),4566 4567.
Smithson,A.E.,2000.RethinkingthelessonsofTokyo.In: Smithson,A.E.,Levy,L.E.(Eds.),Ataxia:TheChemical andBiologicalTerrorismThreatandtheUSResponse. StimsonCenterReportNo.35.SimpsonCenter,WashingtonDC,pp.71 111.
Takahashi,H.,Keim,P.,Kaufmann,A.F.,Keys,C., Smith,K.L.,Taniguchi,K.,Inouye,S.,Kurata,T.,2004. Bacillusanthracis incident,Kameido,Tokyo,1993.Emerg. Infect.Dis.10(1),117 120.
Tu,A.T.,2002.ChemicalTerrorism:HorrorsinTokyo SubwayandMatsumotoCity.FortCollinsCO:Alaken Inc.
Turnbull,P.(Ed.),2008.AnthraxinHumansandAnimals, fourthed.WorldHealthOrganization,Geneva.
TheFBI’sAmerithraxTaskForceandthe adventofmicrobialforensics R.ScottDecker,TerryL.Kerns
Bio-LogicSecurity,LLC,LasVegas,NV,UnitedStates
Concernforthefuture The1990ssawadramaticriseinawarenessof theuseofbiologicalweaponsandterrorism. SecretaryofDefenseWilliamCohenstartled thenationoneSundaymorningbyequating theamountofanthrax1 powderwithabagof sugaranditscapabilitytokillone-halfofWashington,D.C.’spopulation;UnitedNation’ s inspectorsuncoveredtheextentofIraq’sbiologicalweaponsprogram;RichardPreston’sbestsellingbook, TheHotZone,followedby The CobraEvent broughtmicrobesgoneawrytothe public’seye(Decker,2018).
Thoseingovernmentcirclestooknoteand realizedthenationwasunpreparedforabiologicalattacktheyfearedwasloomingonthehorizon.IntheFederalBureauofInvestigation(FBI) LaboratoryDivision,DeputyAssistantDirector RandallS.Murchstoodupanewunit,the HazardousMaterialsResponseUnit(HMRU). Itsmissionwastorespondtocrimescenes involvinguseofaweaponofmassdestruction,
collectandpreservetheevidence,andcoordinateitsforensicexploitation.AttheCentersfor DiseaseControlandPrevention(CDC),US PublicHealthServicemedicalofficerScottLillibridgewiththehelpofmicrobiologistStephen A.MorseinitiatedtheBioterrorismPreparedness andResponseProgram(BPRP).Richard F.MeyerfromPlumIslandandRichardB.KelloggsoonjoinedMorse,andtheybeganidentifyingstate-of-the-arttechnologyfor characterizingmicrobes.
LaboratoryResponseNetwork InadditiontobuildingtheCDC’sBPRPand theFBI’sHMRU,MorseandMurchdeveloped theideaforanationalLaboratoryResponse Network(LRN) aconceptsimple,elegant, andnovel highlyeffectiveandefficient.The CDC’sheadquartersinAtlantahostedthe January1999kick-offmeeting.Attendees includedrepresentativesfromtheDepartments
1 Anthraxisdefinedasthediseasecausedbythebacterium, Bacillusanthracis.However,inconversationalusage, anthraxand Bacillusanthracis areoftenusedinterchangeably.
oftheArmyandNavyandtheAmericanPublic HealthAssociation.Toppublichealthofficials fromaroundthecountryandtheFBI’sLaboratoryDivisionjoinedthem.Thatmeetingbegan effortsforthestandardizationofmethodsand useofequipmentforthedetectionandidentificationofmicrobesusedinbioterroristandcriminalevents.
TheDepartmentofHealthandHuman ServicesthroughtheCDCrebuiltthenation’ s publichealthinfrastructurebyprovidingfunds tostateandlargecountypublichealthlabsfor thepurchaseofstate-of-the-artequipmentfor microbiologicalidentification.Atthesame time,scientistsfromnationalinstitutionssuch astheUnitedStatesArmyMedicalResearch InstituteofInfectiousDiseases(USAMRIID), theNavalMedicalResearchLaboratory,and CDC’sRichMeyerwoulddevelop,standardize, andvalidateprotocols.Standardizedreagents andtrainingwouldalsobeprovided.Itwasan ambitiousundertaking,butonesoondesperatelyneeded.Inthemonthsfollowing9/11,the LRNwouldprovideinvaluableresourcesand rescuethenationfromnear-panicoverwhite powderlettersandhoaxes.
Whilethepublichealthlabswerewell attunedtoprocessingpublichealthsamples, theynowlearnedtoprocessevidentiary samples.InthePhoenixFBIDivision,for example,agentsaddedchainofcustodydocumentationtotheexistingpublichealthaccession paperworkandprocessesweredevelopedfor cross-referencingevidentiarysampleswith publichealthcatalogingsystems.Onarrivalat anLRNmemberlab,theFBI’sevidencewould bestoredinadedicatedandsecurearea. Followingtestingforbiologicalthreatagents, laboratorypersonnelwouldtransferthe evidencetoasecond,secureareatoavoid cross-contaminationwithnewincoming samples.Entrytosecureareaswaslimitedand recordsofingress/egressmaintained.Following
intakeofsuspectedsamples,theLRNlabswould communicatedailywiththesubmittingFBI field of fice;testresultswererelayedimmediatelyto victimsandtheirdesignatedhealthcare professionals.
TheequipmentprovidedtotheLRNwas availableforday-to-daypublichealthwork, andintheinstanceofasuspectedbiological attackorthreat,availabletoanalyzeevidence collectedthroughthecoordinationofFBIJoint TerrorismTaskForces.Evidencethattestedpositiveforapathogenortoxin(e.g.,ricin)wouldbe transferredtoanational-levelfacility CDCora Washington,DCareaDepartmentofDefense lab forconfirmationandforensicanalysis. Specializedtesting,suchasgenomeanalysis, wouldtakeplaceatpartnerlaboratoriessuch asPaulKeim’slaboratoryatNorthernArizona University.
Theprimaryadvantageofusinglocalfacilities wastimelyturnaround.In1998,anythreatening material,suchasanenvelope filledwithapowder,wastransportedtoanational-levellabfor testing,takingdaysbeforeananswer,usually negative,couldbegiventovictims,risking unnecessaryadministrationofantibioticsorin thecaseofapositivetest,costlydelay.Should thecountrybedelugedwithanthraxhoaxletters asin1998,thevolumeoftestingwouldthreaten tooverwhelmnationalassets.
Beginningin1998,theFBIaddedmicrobialforensicstoitslistofavailableinvestigative approaches.Itbuiltandstrengthenedrelationshipswiththecountry’smicrobiologyexperts andwasabletoproviderudimentarytestingto its fieldof ficesaroundtheUnitedStates. ContractsandMemorandaofAgreementwere putinplaceasvehiclesforfundingandreimbursement.Microbialforensicswouldnotbea stand-alonetooltoproveinnocenceorguilt, butoneofmanyavailabletogenerateinvestigativeleads(Fig.2.1).
FIGURE2.1 Flowchartforinvestigationofuseofabiologicalweaponofmassdestructionaspresentedto firstresponders andpublichealthpersonnelbytheauthorswhileassignedtotheFBI’sHazardousMaterialsResponseUnit(c.1998 2001).
Post-9/11:thesecondwaveofattack TheeventsofSeptember11,2001,areoneof thosedaysinhistorythateveryonewill rememberwheretheywere.ThenearsimultaneousairlinerattacksontheWorldTradeCenter towers(Fig.2.2)andthePentagon,alongwith thedivertedattacktoacoalfieldinPennsylvania, remainscorchedinournationalcollectiveness alongwithJapan’s1941attackonPearlHarbor andthe1963assassinationofPresidentJohnF. Kennedy.
MembersoftheFBI’sHMRUrespondedtoall threeofthe9/11crimescenes.InNewYorkCity, epidemiologistsfromtheCDCbeganmonitoringareahospitalsformysteriousillnesses.
FIGURE2.2 TheGroundZeroPile.ACaterpillarexcavatorclearssteelandconcretefromthewreckageofManhattan’ s WorldTradeCentercomplexfollowinganattackbyhijackedcommercialairlinersonSeptember11,2001.
Concernranthroughgovernmentofabiological bombaboardoneoftheairliners.Officials worriedaboutabiologicalattackcomingon theheelsof9/11.AroundWashington,D.C., theDepartmentofEnergydeployeditsBiologicalAerosolSentryandInformationSystem (BASIS)technologytosampletheairforbiologicalaerosols, Bacillusanthracis atthetopoftheir list.USAMRIIDtestedthesmall filterscollected hourlyfromBASISmonitoringstations deployedthroughouttheNationalCapital region.Whilethelocationsofthestationswere confidential,USAMRIIDstaffwereawareof thetesting,anditgeneratedspeculationabout whatwascomingnext.
Threeweeksafter9/11,earlyinthemorning, RobertStevensofsouthFloridaadmittedhimself totheJFKMedicalCenterlocatedbetweenWest PalmBeachandBocaRaton.Hehadbeen vomitingandincoherentduringthenight.By thetimehearrivedatJFK,deliriumhadtaken over.Initially,doctorssuspectedbacterialmeningitisandadministeredmultipleantibiotics. Sixhourslaterhesufferedaseizureandwas placedonaventilator(Cole,2003).Farther south,Stevens ’ coworker,ErnestoBlanco,a mailroomworkeratAmericanMedia,Incorporated(AMI)checkedhimselfintoMiami’sCedarsMedicalCenterashebecameincreasingly disorientated.Themedicalstaffsoonadministeredintravenousantibioticsandhookedhim uptoamechanicalrespirator.AdefinitivediagnosisforBlancowouldeludethemfordays.
AnexaminationofStevens’ cerebrospinal fluidrevealedgram-positivebacilliandaFlorida PublicHealthlaboratory,usingthenewLRN protocols,identi fiedthebacteriaas B.anthracis, 44hafterStevenswasadmittedtoJFK.ThebacteriaweresenttoAtlantawheretheCDC’sBPRP confirmedthediagnosisofanthrax.BPRPstaff inoculatedsamplesofStevens’ B.anthracis onto anagarslantand flewittoNorthernArizona University.There,workingthroughthenight, PaulKeimandhisstaffidenti fiedthe B.anthracis astheAmesstrain,aresearchstrain
usedtoassessvaccineef ficacy.Atthesame time,theCDC’sAlexHoffmaster,usingthe MultipleLocusVariableNumberTandem Repeat(VNTR)Analysis(MLVA)developedby theKeimlab,confirmedtheAmesidenti fication (Keimetal.,1997,2000).FindingthatalaboratorystraininfectedStevensandnotanunknown environmentalstrainpointedtowardanintentionalact potentiallythe firstactofdeadly bioterrorismintheUnitedStates.OnOctober 5,2daysafterenteringJFKMedicalCenter,Stevenssuccumbed.Hewasthe firstcaseoflethal inhalationalanthraxintheUnitedStatessince 1976.
Blanco’sdiagnosiswasnotasstraightforward.RepeatedattemptstoidentifyviablebacteriainBlancofailed.TheCDCcasedefinition requiredviable B.anthracis foradiagnosisof anthrax.However,inhisRapidResponseand AdvancedTechnologylabatCDC,RichMeyer hadvalidatedanewassay,ahighlysensitive andquantitativeimmunoassayhetermed Time-ResolvedFluorescence(TRF).Applying TRFtoBlanco’spleural fluid,Meyerdetected highlevelsofinert B.anthracis antigens, convincingMeyerthatBlancohadinhalational anthrax.ButCDCexecutiveleadershipneeded moreconvincing.Afterseveraldaysoftensionfilledmeetingsandtersediscussions,theCDC frontofficeagreedthatErnestoBlancowasthe secondinhalationalanthraxvictimsince1976 (Blanco’scasewouldleadtotheCDCrevising theircriteriaforanthraxdiagnosis).Whilethe extraordinaryhighlevelsofintravenousantibioticsmayhaveconfoundedanearlydiagnosis, theyundoubtedlysavedBlanco’slife.Hewould goontoafullrecovery(UCLA,FieldingSchool ofPublicHealth).
OnFriday,October12,2001,9daysafterStevens ’ initialdiagnosis,suspicionsofa bioterroristattackwerecon firmed.Afteracircuitoussearch,aletteraddressedtoNBCnews anchorTomBrokawinManhattanwasrecoveredcontainingdry B.anthracis spores.The envelopewaspostmarked “Trenton,NJ.” Three
dayslater,asecondspore-filledletterwasrecoveredintheCapitolHillof ficesofUSSenatorTom Daschle thehandwritingandeagleprestampedenvelopeidenticaltotheBrokawletter. However,theDaschleletter,alsopostmarked “Trenton,NJ,” boreaNewJerseyreturn address whichprovedtobefake.OneweekafterrecoveringtheBrokawletter,a B.anthracis filledletterwasrecoveredaddressedtotheeditorofthe NewYorkPost inManhattan.Inearly November,aletter filledwithsporeswasrecoveredinquarantinedmail.Thisonewas addressedtoUSSenatorPatrickLeahy.Four letterswererecoveredinall,the Post andLeahy letterswereunopened.RecoveryoftheLeahy letterallowedforarangeofdestructiveforensic analyses.
ThetwoletterssenttoNewYorkCity containedgranulardarkbrowndriedspores mixedwithdebris;thetwoCapitolHillletters senttoDaschleandLeahycontainedlightgray powder,very fineandlittletonodebris (Fig.2.3).Thedriedpowderintheseletters consistedoftinyclumpsofsporesandsingle
spores.WhentheDaschleletterwasopenedin hisoffice,thepowderbehavedasanaerosol andspreadthroughofficebuildingsonCapitol Hill.Cleanuptookmonths.InNewJersey, NewYork,Maryland,Washington,D.C.,Florida,andConnecticut,victimspresentedwith cutaneousandinhalationalanthrax.Bytheend ofNovember2001,therewere22totalcasesof anthrax,11inhalationaland11cutaneous.The inhalationalformclaimed fivelives,onein Florida,oneinConnecticut,twoinMaryland, andoneinNewYorkCity.Seventeenofthe victimsrecoveredfromtheirinfection;many remaindisabledordis figured.
Qualityofsporematerial behavioral assessment TheSenateletterswereofthegreatestinterest intermsofpurityandconcentration.Estimates arethat0.8 1.0gofpowder filledtheletter mailedtoSenatorLeahy,withadensityof 2 1012 sporespergram.The NYPost letter materialwasofconsiderablylesserpuritywith estimatesof2 1011 sporespergram.Forthe twoCapitolHillletters,thetwoNewYorkletters andassumingoneletterattheAMIbuilding,the FBILaboratoryestimatedtheattackermailed approximately3.7 1012 spores.Conclusions abouttheamountoftimerequiredtoproduce thematerialvariedwidely,from2to3daysto months,assumingliquidcultureinshaking flasksorafermenter(Gastetal.,2011).
StudiesofthematerialintheDaschleand Leahylettersrevealedabimodalparticledistribution.Thepowderconsistedofsinglespores witha1.5umdiameterthatrepresented1%of thetotalsporemass.Theremainderconsisted ofclumpsapproximately20umindiameter. Thesemeasurementswereconductedwithan Aerosizer(TSI,Inc.)followingaerosolizationof thepowder.Scanningelectronmicroscopy (SEM)confirmedabimodalparticledistribution:
FIGURE2.3 Powderofdried Bacillusanthracis spores recoveredfromenvelopeandletteraddressedtoUSSenator Patrick.
singleparticleswithamorphologyconsistent with B.anthracis sporesandclustersofspores. However,thepowderwassubjectedtoautoclavingbeforeSEManalysisandthatmayhave affectedsizedistribution(Gast).
Thelevelofpurityprovidedaforensicclueto thesophisticationofthematerial’sproducer(s). ThetransitionofthecrudeNewYorkletter materialwithin3weekstothe finepowderin theCapitolHilllettersindicatedaquicklearner andastutemicrobiologist.Thisinformation wasfactoredintothebehavioralassessment beingdevelopedbyFBIprofilersinQuantico.
AmerithraxTaskForce AnthraxvictimswerelocatedinsixFBIdivisions,butFBIheadquartersrecognizedthe attackswerelikelytheworkofonepersonora singlegroupandconsolidatedthegrowing investigation.TheWashingtonFieldOffice (WFO)inWashington,D.C.wasdesignated OfficeofOrigin(OO).InFBIparlance,theOO wouldbearresponsibilityforsolvingthecase.
TheWFOquicklyformedataskforce;headquartersgavetheinvestigationacodename, AMERITHRAX(AMX).ItincludedFBIagents withsciencebackgroundsandUnitedStates PostalInspectionServiceinspectors.Together withscientistsfromtheFBILaboratory’ s ForensicScienceResearchUnit,thescience agentsbeganbrainstormingsessions.Originally, itwashopedthatforensicmethodsalreadyin placeattheFBIwouldprovideinvestigative leads,butthosehopesquicklydissipated.The envelopeshadbeentapedshut,andtherewere nostampswithwater-solubleadhesive,leaving littlehopeforrecoveringhumanDNA.Nor werelatentimpressionsfoundthatcouldbe fedintotheAutomatedFingerprintIdentificationSystem.Examinersquicklydetermined thattheinkusedtowritetheenvelopes’ addresseswascommonandofnovalueforattribution.Neitherlettersnorenvelopescontained
indentedwriting.Themailboxusedtopostthe letterswaseventuallylocatedinPrinceton,NJ, butasearchoftheareaturnedupnosurveillance cameras.Trafficcitationsissuedintheareawere ofnovalueandnearbyshopownersandresidentsprovidednoclues.
Thebrainstormingsessionsidentifiednovel scienceapplications.Consideredwerestable isotopeanalysisforattributiontoageographic area;thepresenceofhemoglobinasanindicationbloodagarhadbeenusedtoculturethe microorganism;originofthesiliconidentified inthesporecoat;datingthesporeswith carbon-14;analysisofplasmidDNAformutationsspecifictothemailed B.anthracis .Ofthe techniquesconsidered,threeprovidedleadsor corroboratedinvestigativeconclusions.
ColonymorphologyandDNAsequencing Asoftenhappensinscience,greatdiscoveries beginasaccidents,followedbyastuteobservations.Suchwasthebiggestleadintheanthrax investigation.Whilecharacterizingthespores fromtheDaschleand NYPost letters(mostof thepowderintheBrokawletterwaslostbefore itstransportationtotheCDC),USAMRIID microbiologistTerryAbshiresetupculture platesanddilutedthesporestoallowsingle colonypropagation.Ononeoccasion,shelet theplatesremainintheincubatorat37 C,rediscoveringthemseveraldayslater.Shenoticeda minorityofthecolonieshadmorphologies differentthanthepredominantwild-type B.anthracis.Basedontheirexperience,Abshire andhersupervisor,JohnEzzell,suspectedthe variantsmightbeduetomutationsinthesporulationpathway.
PatriciaWorsham,alsoaUSAMRIIDmicrobiologist,wastheinstitution’sexpertonbacillus sporulation.ShebeganworkingwiththeAmerithraxTaskForcetocharacterizethemorphology variants soonknownas “morphs.” Shefound theminallthreeletters,Daschle,Leahy,and
NYPost.Thevariantswerestableinculture,an indicationofbeingtheresultofDNAmutation. SheisolatedseveralanddesignatedthemA1, A2,A3,B,C,D,andE,estimatingthey accountedfor10%ofthetotalcolonies.
Luck,fueledbypersistenceanddeliberation, comesintoplayduringlawenforcementinvestigationsaswellasthoseofscience.Duringaconsentsearchofrefrigeratorsinconjunctionwith interviewsofUSAMRIIDpersonnel,theoriginal agarslantoftheAmesisolatewasdiscovered.Its tubewasdatedFebruary1981andviablespores remained.Findingthe1981AmesgavetheFBI anidealcandidatetoprovideabaseline,unalteredDNAsequenceofthegenomefromthe originalsample(Raveletal.,2009).Apioneer inwholegenomesequencing,TheInstitutefor GenomicResearch(TIGR)ofRockville,MD, wassoonunderagreementtoperformthework.
Beforetheisolationandinitialcharacterizationofthemorphologyvariantsandwhole genomesequencingofthe1981Ames,theFBI hadbegunanambitiousproject.Beginning withselectagenttransferregulationrecords fromtheCDC,coupledwithliteratureandpatentreviews,and fieldinterviews,theFBItracked downlocationsoflaboratoriespossessingthe Amesstrainof B.anthracis.Theeffortwould takeagentsto16laboratoriesintheUnited States,laboratoriesinCanada,theUnited Kingdom,andSweden;theinvolvementofat leastoneforeignembassyandtwotripsacross theAtlanticbyprivateaircraft.Collecting Amessamplesbeganinthefallof2001and wascompletedduringfall2006(Fig.2.4).
Followingcompletionofthe1981Ames’ genomeDNAsequence,TIGRbegansequencing DNAisolatedfromthemorphologyvariants. WorshamisolatedandpropagatedA1-3,B,C, D,andEcolonies;thebacteriaweretransferred toPaulKeimforDNAisolation(TIGRwasnot approvedtoworkwithliveselectagents);the DNAwassenttoTIGRforgenomesequencing; andlastly,samplescontainingputativemutationsreturnedtoKeimforconfirmation.All
FIGURE2.4 Oneof1082samplesof Bacillusanthracis Amesstraincollectedworldwide.EachsamplewassubmittedtotheFBIrepositoryinduplicate.Oneoftheduplicates sampleswassenttoPaulKeimattheNorthernArizona Universityforstrainconfirmationandemergencybackup storageincaseoflossofpower, fire,waterlinebreak,etc., atUnitedStatesArmyMedicalResearchInstituteofInfectiousDiseases. PhotocourtesyofTomReynolds,NEXTMolecularAnalytics,LLC.
scientistsreceivedcodedsamplesanddidnot knowtheiridentityororigin.
During2003,theeffortsoftheFBI,Worsham, Keim,andTIGRbegantopayoff.TheBvariant’ s morphologywasattributedtoasinglepoint mutation thiswouldproveunrealisticfor developingascreeningassaywithtechnology thatwasavailable.However,anAvariantwas foundtocontaina2024basepair(bp)insertion inoneoftheeleven16sRNAgenes.Thisinsertionwasamenabletodevelopingascreening assay.Mutationswerealsoidenti fiedinadditionalA,andC,D,andEvariants(Raskoetal., 2011).Foracompletelist,seethe2011report fromtheNationalResearchCouncilofthe NationalAcademyofSciences(Gast).
TheFBIcontractedthecomparisonofthe evidentiarymorphologyvariantsandtheAmes exemplarsintheirrepositorytoCommonwealth Biotechnologies,Incorporated(CBI).Withthe identificationofthemorphologymutations, CBIbegandevelopingTaqmanreal-time polymerasechainreaction(PCR)assays.The FBIimposedstrictspeci fications.Eachsample initsAmesrepositorywouldbescreenedin